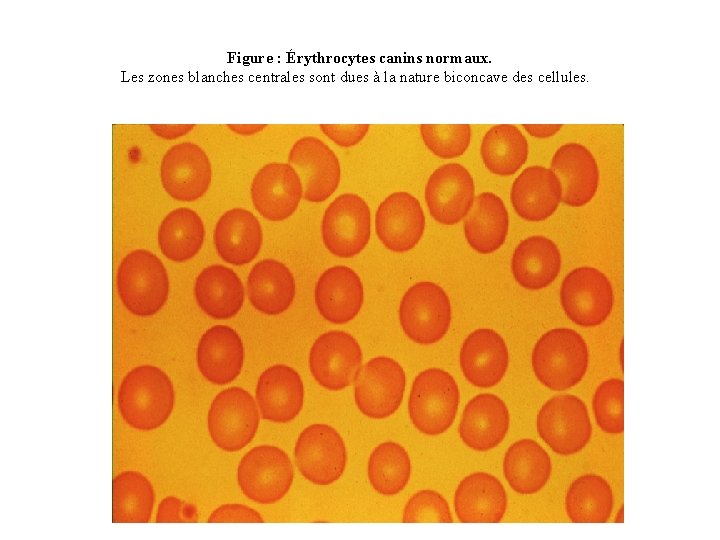
Figure : Érythrocytes canins normaux. Les zones blanches centrales sont dues à la nature
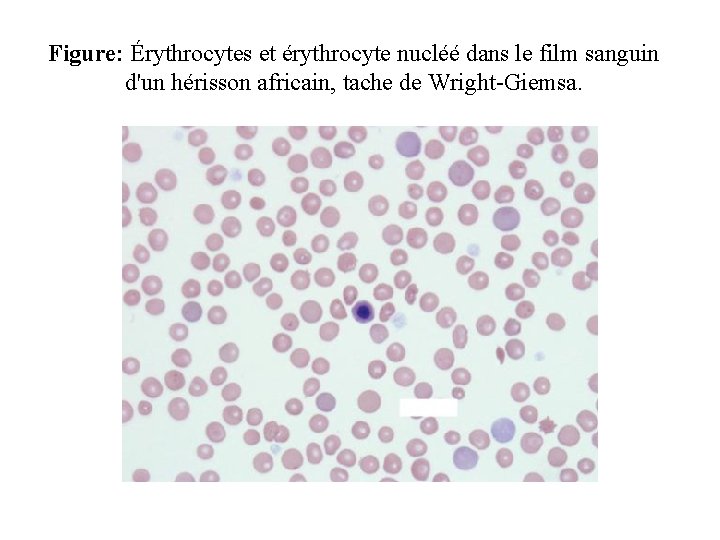
Figure: Érythrocytes et érythrocyte nucléé dans le film sanguin d'un hérisson africain, tache de
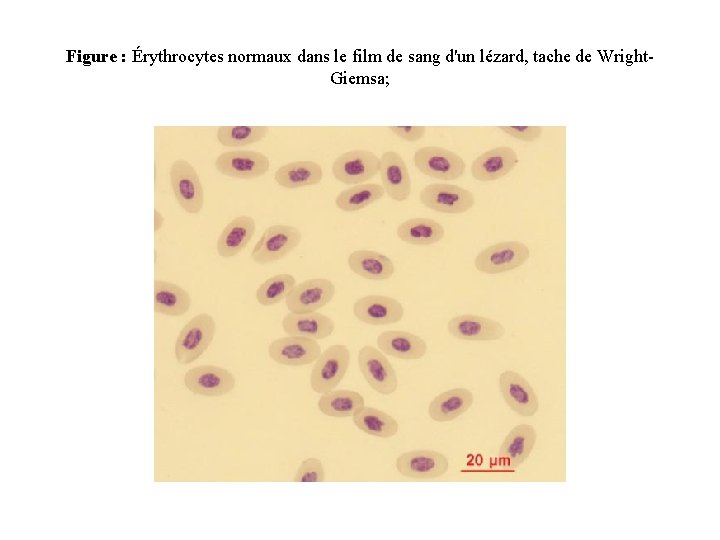
Figure : Érythrocytes normaux dans le film de sang d'un lézard, tache de Wright.
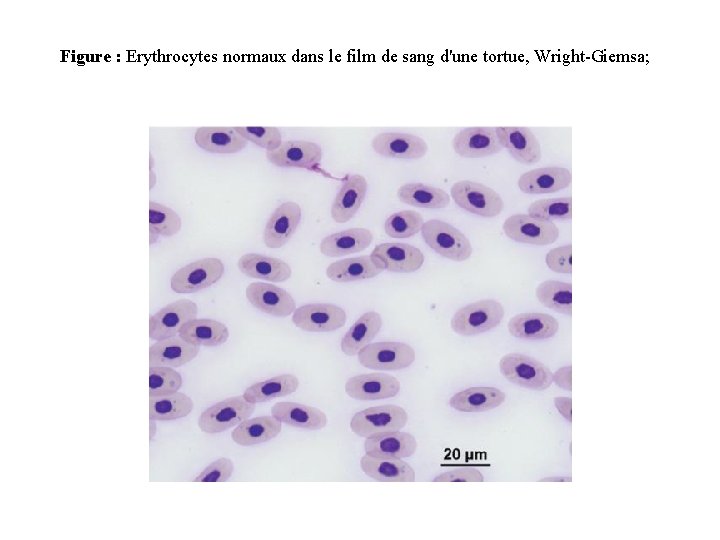
Figure : Erythrocytes normaux dans le film de sang d'une tortue, Wright-Giemsa;
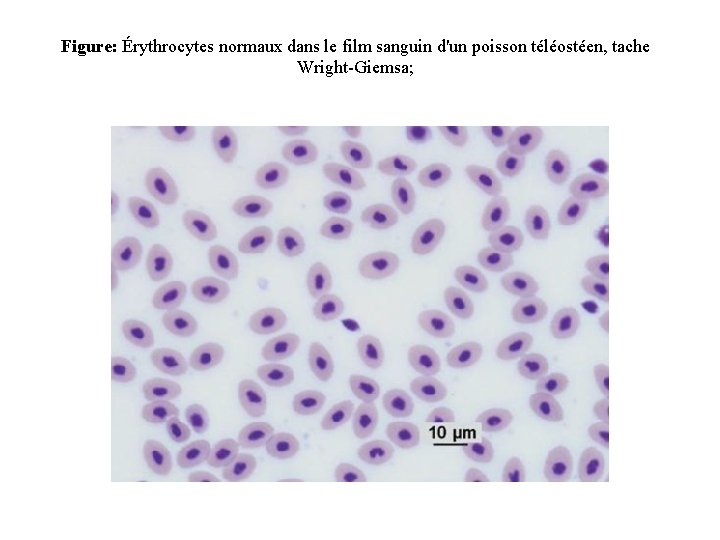
Figure: Érythrocytes normaux dans le film sanguin d'un poisson téléostéen, tache Wright-Giemsa;
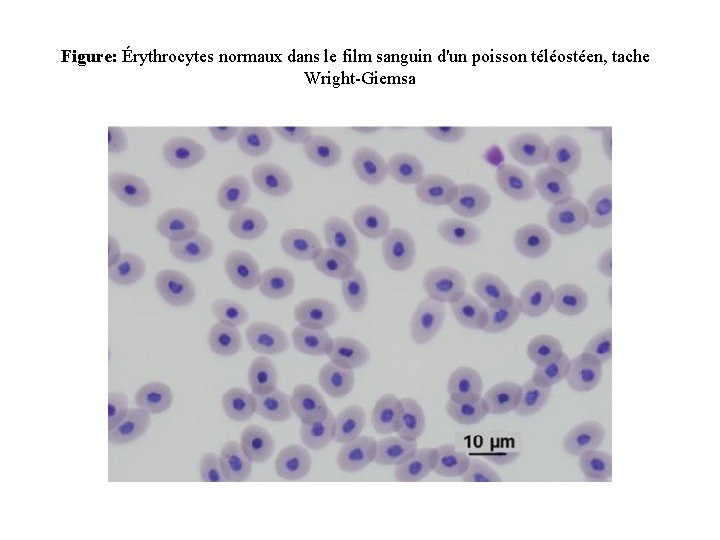
Figure: Érythrocytes normaux dans le film sanguin d'un poisson téléostéen, tache Wright-Giemsa

Les cellules du sang Le sang contient des

- Slides: 25
Les cellules du sang Le sang contient des cellules anucléées, les hématies (également nommées globules rouges (érythrocytes), de cellules nucléées, les leucocytes (ou globules blancs) et de fragments de cytoplasme, les plaquettes (ou thrombocytes). Leur origine est médullaire, provenant d'une même cellule souche hématopoïétique totipotente, après intervention directe ou indirecte de facteurs de croissance hématopoïétiques agissant sur la différenciation et la maturation de lignées cellulaires médullaires, avec passage dans le sang d'éléments ayant fini leur maturation
Les hématies L'hématie, cellule anucléée, a pour fonction première de transporter l’oxygène dans l’organisme. Sa production est finement régulée par la production d’une hormone, l’érythropoïétine (EPO), par les cellules du rein selon la concentration d’oxygène disponible dans ce tissu. Elle se compose d’une membrane et d’un cytoplasme. La membrane de l’hématie est très complexe composée d’une bicouche lipidique, de glycoprotéines membranaires dont certaines supportent les antigènes de groupes sanguins et de protéines de soutien dont la spectrine, véritable cytosquelette au rôle prépondérant dans le maintien de la forme en disque biconcave, indispensable à la survie de la cellule. Cette membrane permet les échanges entre plasma et cytoplasme. À sa surface, les charges électronégatives assurent une certaine force répulsive (empêchant les hématies de s'agglomérer (potentiel Zêta)
Le cytoplasme, outre de l'eau (65% du poids de la cellule), contient des ions minéraux (K+, Na+, Ca++. . . ), du glucose en provenance du plasma (nécessaire au métabolisme énergétique) et deux constituants essentiels de nature protéique : l'hémoglobine (Hb) et l’ensemble des enzymes érythrocytaires. L'hémoglobine (environ 34% du poids du globule, 300 millions de molécules par cellule) est un tétramère constitué de deux dimères associant 1 chaîne α et 1 chaîne autre que α (dans les conditions physiologiques β et δ ou γ selon l'âge). À chacune des 4 chaînes de globine est accroché un groupe prosthétique (non protéique), l'hème contenant un atome de Fer. C'est sur cet atome de fer que vient se fixer la molécule d'O 2 transportée.
Les enzymes érythrocytaires de la glycolyse fournissent l'énergie nécessaire à la survie de l’hématie. Cette énergie, sous forme d'ATP, joue un rôle essentiel dans le maintien structural et fonctionnel de la membrane érythrocytaire tandis que d'autres nucléotides associés à d'autres enzymes protègent l'hémoglobine de l'oxydation. Un métabolite intermédiaire de la glycolyse intraérythrocytaire, le 2 -3 di phospho glycérate (2 -3 DPG) joue un rôle capital dans la régulation de la fixation de l’oxygène à l'hémoglobine en influençant la courbe de dissociation de l'hémoglobine.
La survie de l'hématie dans la circulation est d'environ 120 jours dans les conditions physiologiques. Elle nécessite l'aptitude de l'hématie à se déformer pour traverser les capillaires les plus étroits de la circulation, en particulier dans la rate, le foie et la moelle osseuse. Cette déformabilité exige le maintien des propriétés de la membrane et la fourniture d'énergie dont la disponibilité est limitée dans le temps (épuisement du stock d'enzymes érythrocytaires). A terme, les cellules vieillies deviennent rigides et sont retenues, dans les conditions physiologiques, au niveau de la moelle osseuse essentiellement. Elles sont alors phagocytées par les macrophages : c'est l'hémolyse physiologique (ou érythrolyse).
Le globule rouge humain Un érythrocyte normal se présente de profil comme un disque à centre clair: c’est une sorte de poche contenant l’hémoglobine. Cette forme lui confère une élasticité importante, qui permet le transport de dioxygène à travers certains capillaires étroits. Le diamètre normal des globules rouges de face varie de 6, 7 à 7, 7 micromètres (moyenne 7, 2 Vus au microscope optique à l’état frais, ils sont de couleur rouge-orangé; sur un frottis mince coloré au May-Grunwald Giemsa ou à la coloration de Wright, ils apparaissent plus rose. Leur forme est très bien visualisée au microscope électronique à balayage (MEB). Sur frottis épais, les globules rouges se disposent volontiers en rouleaux (particulièrement en en présence d’un excès fibrinogène) et sont alors vus de profil.
Lignée érythrocytaire Production de globules rouges ou érythropoïèse Précurseur : macro normoblaste → érythroblaste basophile → érythroblaste poly-chromatophile → érythroblaste acidophile → réticulocyte (sang, jeunes globules rouges de 24 h) Durée : 7 jours Nécessité : Fer, vitamine B 9, B 12, Zn++, acides aminés. . . Numération : appareils compteurs * Taux de globules rouges § Homme : 4, 5 à 6 M/mm 3 § Femme : 4 à 5, 5 M/mm 3 § Nouveau-né : > 6 M/mm 3
Lignée érythrocytaire
Figure : Érythrocytes canins normaux. Les zones blanches centrales sont dues à la nature biconcave des cellules.
Erythrocytes mammifères Les érythrocytes dans les films de sang de mammifères sont anucléés, ronds (sauf ceux provenant de camélidés) et biconcave. Les films de sang colorés par Romanowsky provenant de mammifères révèlent souvent des érythrocytes avec une zone distincte de pâleur centrale résultant de leur biconcavité. Cette forme permet un échange efficace d'oxygène en permettant au globule rouge de déformer sa forme pour se déplacer à travers des vaisseaux sanguins d'un diamètre plus petit que le sien. La morphologie des érythrocytes dans le film de sang coloré est utile pour fournir des indices quant à la nature des troubles des globules rouges, une telle anémie. Diagnostiquement, les caractéristiques morphologiques importantes des érythrocytes de mammifères comprennent les érythrocytes poly chromatiques, hypo chromatiques, microcytaires et macrocytaires; Poikilocytose; Et inclusions de globules rouges. Les structures érythrocytaires importantes comprennent les corps de Heinz, les pointillés basophiles, les érythrocytes nucléés et les corps de Howell-Jolly.
Figure: Érythrocytes et érythrocyte nucléé dans le film sanguin d'un hérisson africain, tache de Wright-Giemsa.
Érythrocytes aviaires Les érythrocytes aviaires adultes sont généralement plus grands que les érythrocytes de mammifères, mais plus petits que les érythrocytes reptiliens. Les érythrocytes aviaires varient selon leur espèce, mais ils varient généralement entre 10, 7 × 6, 1 et 15, 8 × 10, 2 μm. EX: Les érythrocytes de cailles adultes de Coturnix, mesurent 11, 06 ± 0, 70 μm de longueur et 6, 80 ± 0, 67 μm de largeur chez les mâles et 11, 40 ± 0, 63 μm de longueur et 6, 73 ± 0, 45 μm de largeur chez les femelles. Les érythrocytes aviaires adultes sont elliptiques et ont un noyau elliptique centralement positionné. La chromatine nucléaire est uniformément agrégée et se condensant de plus en plus avec l'âge. Dans les films de sang colorés par Wright, le noyau tache violet, tandis que le cytoplasme taches orange-rose avec une texture uniforme. Afin de pallier à la grande demande en oxygène, les érythrocytes ont tendance à être plus petits chez les oiseaux adaptés aux vols de longue distance, leur procurant ainsi une meilleure surface d’échange gazeux. À cause de la faible capacité des GR aviaires à se déformer, le sang des oiseaux est très visqueux. Cette lacune est cependant compensée par l’importante densité capillaire. Le métabolisme et la température corporelle élevée des oiseaux ont pour effet d’écourter la durée de vie des GR. En effet, la durée de vie des érythrocytes varie de 28 -35 jours chez le poulet, de 35 -45 jours chez le pigeon, de 33 -35 jours chez la caille, d’environ 42 jours chez le canard versus 100 -115 jours chez le chien, environ 120 jours chez l’homme et 73 jours chez le chat.
Figure: Érythrocytes normaux dans le film sanguin d'un poulet domestique (Gallus gallus domesticus), tache de Wright-Giemsa; Figure: des érythrocytes normaux dans le film sanguin d'un perroquet (Eclectus roratus), tache de Wright. Giemsa;
Érythrocytes des reptiles Les érythrocytes adultes des reptiles sont généralement plus grands que les érythrocytes des oiseaux, des poissons osseux et des mammifères, mais ils sont plus petits que les érythrocytes de la plupart des amphibiens. Les érythrocytes des reptiles sont des cellules ellipsoïdales à extrémités franches avec des noyaux permanents, centralisés, ovales à ronds, contenant une chromatine pourpre dense. Contrairement aux marges nucléaires lisses des érythrocytes aviaires, celles des reptiles ont tendance à être irrégulières. Les taches de cytoplasme uniformément orange-rose avec des taches Romanowsky comme la tache de Wright. Les érythrocytes poly chromatophiles ont une chromatine nucléaire moins dense et un cytoplasme plus basophile que les érythrocytes matures. Des érythrocytes immatures sont parfois observés dans le sang périphérique des reptiles, en particulier des animaux très jeunes ou ceux qui subissent une ecdysie. Les érythrocytes immatures sont des cellules rondes à légèrement irrégulières avec de gros noyaux ronds et un cytoplasme basophile. Le noyau ne possède pas l'agglutination dense de la cellule mature. Les érythrocytes immatures apparaissent souvent plus petits que les érythrocytes matures, probablement parce qu'ils sont de forme sphérique et n'ont pas encore été aplaties Ellipsoïdes. L'activité mitotique associée aux érythrocytes est courante dans le sang périphérique des reptiles.
Figure : Érythrocytes normaux dans le film de sang d'un lézard, tache de Wright. Giemsa;
Figure : Erythrocytes normaux dans le film de sang d'une tortue, Wright-Giemsa;
Figure : Érythrocytes normaux dans le film sanguin d'un serpent, tache de Wright. Giemsa.
Les érythrocytes des amphibiens sont grands comparés à ceux d'autres vertébrés dont les tailles varient de 10 à 70 μm de diamètre. La plupart des érythrocytes amphibiens sont nucléés et de forme elliptique, ont un renflement nucléaire distinct, et ont souvent des marges nucléaires irrégulières. Certains amphibiens, tels que la salamandre mince, n'ont pas de globules rouges nucléés. Le cytoplasme des érythrocytes de grenouille et de crapaud est homogène et est rempli d'hémoglobine. Les érythrocytes des salamandres et des tritons complètent leur maturation dans la circulation périphérique; Par conséquent, le cytoplasme des érythrocytes immatures n'est pas homogène et l'examen ultra structural démontre des grappes de corps granulaires et vacuolaires. Le cytoplasme des cellules immatures également taches plus basophiles comparé aux cellules matures avec la tache de Wright. La coloration bleue du cytoplasme érythrocytaire amphibien peut également être associée, en partie, aux effets de l'héparine sur les films de sang colorés par Wright car l'héparine est un anticoagulant couramment utilisé lors de la collecte du sang chez les amphibiens.
Figure : Érythrocytes normaux dans le film sanguin d'une salamandre, tache de Wright-Giemsa
Les érythrocytes des poissons téléostéens sont semblables en apparence et ultra structure à ceux des oiseaux et des reptiles. Les érythrocytes matures des poissons élasmobranches sont également semblables en apparence aux érythrocytes aviaires et reptiliens, mais sont beaucoup plus grands. Les érythrocytes mûrs normaux du poisson sont ovales à ellipsoïdales avec un cytoplasme éosinophile pâle abondant et des noyaux ovales à ellipsoïdes positionnés centralement dans des films de sang colorés par Romanowsky Les érythrocytes adultes de certains poissons sont biconvexes avec un gonflement central qui correspond à la position du noyau, alors que d'autres espèces ont des érythrocytes biconcaves aplaties.
Le cytoplasme est typiquement homogène, mais peut contenir des quantités variables de zones ou de vacuoles rares ou pâles qui sont associées à une dégénérescence des organites, comme les mitochondries Les noyaux d'érythrocytes de poisson peuvent être grands et peuvent occuper jusqu'à un quart du volume cellulaire ou plus. Le long axe du noyau est parallèle à l'axe long de la cellule, sauf dans quelques espèces de poissons qui ont des noyaux d'érythrocytes ronds. La chromatine nucléaire est densément agglutinée et taches violet foncé. La taille et le nombre d'érythrocytes varient entre et à l'intérieur des espèces selon les conditions physiologiques présentes. Par exemple, les érythrocytes de poissons appartenant à la classe Chondrichthyes (poissons élasmobranches ou cartilagineux), qui comprennent les requins et les raies, sont généralement plus grands que ceux de la classe Osteichthyes (poissons téléostéens ou osseux).
Figure: Érythrocytes normaux dans le film sanguin d'un poisson téléostéen, tache Wright-Giemsa;
Figure: Érythrocytes normaux dans le film sanguin d'un poisson téléostéen, tache Wright-Giemsa;
Figure: Érythrocytes normaux dans le film sanguin d'un poisson téléostéen, tache Wright-Giemsa
Figure: Érythrocytes normaux dans le film sanguin d'un poisson cartilagineux, tache Wright-Giemsa.